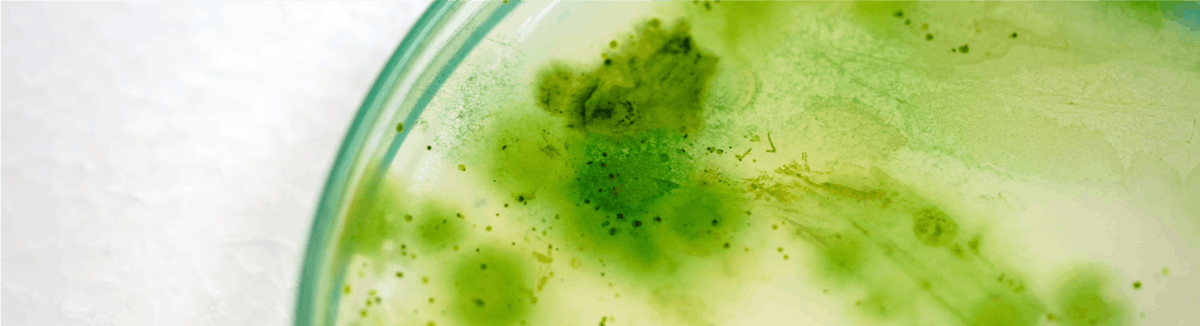
Email Image

VOLUME 2024, ISSUE #3 03/11/2024 |
A MESSAGE FROM OUR DEAN Greetings, Aggies and Friends of the College of ACES, We are getting ready here at the college for our 2024 ACES Open House that will take place on April 6, 2024, from 9am to noon. This is a great opportunity for all the community in ACES, NMSU and Las Cruces to have a glimpse of the activities that our students, faculty, and staff are conducting in the College of ACES. Our college attracts a large amount of external funds to the university, and there is a lot of different research that is conducted within its eight academic departments. Also, our four extension departments will be presenting with exhibits and activities that are conducted in outreach and extension in the college through 4-H, the different districts as well as other important programs of high impact in the lives of New Mexicans. I also want to take this opportunity to thank all the faculty and colleagues that have been intensively involved in the preparation of this important activity for the college and NMSU. In the past years since we started the Open House, we have seen an increase in the number of residents of Las Cruces and Doña Ana County who come to see what is going on in the college. The event has grown over the years, as we continue to welcome the public to visit and learn more about projects and programs within the college. This year, we are excited to welcome a group of ACES alumni all the way from Chihuahua! Please join us for this free and exciting day, which offers something for everyone, including a student research poster competition that allows undergraduate and graduate students to present their ongoing research. Attendees can also tour our new Food Science, Security, and Safety Center. I want to take this opportunity to extend my sincere appreciation to Amy Smith Muise and Heber J. Lara for their invaluable contributions to the preparation and editing of the newsletter. Without their assistance, this project would not have been possible. Thanks to all of you. We look forward to seeing you on April 6 & Go Aggies! |
|
|
4-H Orion Electronic Scoring System Training Twenty 4-H Youth Development professionals and volunteers representing New Mexico, Colorado, and Oklahoma convened February 2 - 4 at the NRA Whittington Center near Raton, NM for the first Western Region 4-H Shooting Sports Orion Electronic Scoring System Training. This training is the first of its kind and was the result of collaborative efforts between the New Mexico and Colorado 4-H programs. The 4-H Shooting Sports Orion scoring system information was shared as participants were introduced to basic Orion electronic scoring system operation, and trained on how the system is currently utilized in various State 4-H Shooting Sports programs. One participant reported, I cannot explain how much more I learned than I was expecting to learn. I am comfortable now setting up a match from start to finish. For more information, contact Sam Lowry, Agriculture and Natural Resource State 4-H Agent at samlowry@nmsu.edu. |
 |
With decreased state funding and diminished school district resources, coupled with an emphasis on high-stakes testing and declining student achievement in science, the Cooperative Extension Service plays an important role in improving youth academic achievement through school enrichment programs. New Mexico State University’s Extension and Research Youth Agricultural Science Center features a unique partnership between NMSU CES and the Las Vegas City Schools' teachers and learners to meet that end. Seventy-one students are investigating variation, selection, and inheritance of an observable plant trait through a guided inquiry-based program at the Center’s greenhouse. Students practice following the steps of the scientific method by posing a research question, developing and testing their hypotheses, designing an experiment, collecting and analyzing data, and communicating results. Students learn the lexicon of genetics, develop plant breeding skills, conduct a 4–month–long experiment, and are engaged in scientific practices that are representative of what scientists do. For more information, contact Peter Skelton at skelton@nmsu.edu. |
 |
Students study the structure and function of a flower through a dissection lab. |
AGRICULTURAL EXPERIMENT STATION |
NMSU Algae for Biofuels Team is Awarded DOE Funding for Continued Research Dr. Alina Corcoran is leading a $2M project funded by the Department of Energy that will kick off in April of this year. This funding comes from $23.6 million to support the production of low-carbon biofuels and bioproducts to reduce greenhouse gas emissions. Dr. Corcoran has already provided novel research to enhance the productivity, stability, and quality of algae strains for biofuels and bioproducts. This new research will focus on predatory bacteria that negatively influence algae biomass productivity. Certain types of bacteria can quickly destroy healthy algae crops. Yet the current understanding of these harmful bacteria, and their management, is lacking. The new project will develop bacteria–algae model systems within which to test antivirulence strategies, such as those used in treating disease in humans. Antivirulence strategies should reduce the risk for treatment resistance and support probiotic microbiomes, promoting an overall healthier system. The Fabian Garcia Science Center is used as part of the outdoor laboratory for this research. For more information on Dr. Cocoran’s research visit www.corcoranalgaelab.com. |
|
|
|
COOPERATIVE EXTENSION SERVICE |
New Mexico State University’s Mora County Cooperative Extension Service will host the AgriVenture Symposium from 9:15 a.m. to 4 p.m. April 10 at the Taos County Agriculture Center, 202 Chamisa Road in Taos, New Mexico. The free event will highlight topics such as regenerative agriculture, soil health, wireless fencing, cattle outlook, climate trends and living with fire-prone landscapes. Register for the event at https://www.eventcreate.com/e/agriventure-symposium-525104.
“This conference plays a pivotal role in addressing contemporary challenges in agriculture by bringing together distinguished experts,” said Sunny Finley, Mora County Ag Extension agent. “The sessions cover a spectrum of issues, from atmospheric conditions and animal health to soil management and fire-prone landscapes. Attendees have the unique opportunity to learn, engage, collaborate and gain valuable insights that are crucial for navigating the complexities of modern agriculture. The networking sessions further promote community building, ensuring a holistic and enriching experience for all participants.” Several subject matter expert specialists will attend and make presentations, including NMSU Climatologist David DuBois on atmospheric science, NMSU Extension Beef Cattle Specialist Craig Gifford on animal physiology, NMSU Extension Agronomy Specialist John Idowu on soil health, and NMSU Extension Forest and Fire Specialist Doug Cram on fire-prone landscapes. For more information, visit https://www.eventcreate.com/e/agriventure-symposium-525104. |
 |
CENTER OF EXCELLENCE IN SUSTAINABLE FOOD & AGRICULTURAL SYSTEMS (CESFAS) |
Food Processing Value can be added to agricultural commodities or products in different ways, e.g., by improving genetics, making products available at a more convenient place or time, improving production and testing technologies, or changing the product's form to make it more useable (food processing). Food processing is a primary way that value is added to agricultural commodities and food products. For example, the farmer’s share of choice beef, relative to the retail price, in 2023 was 47.8%. The difference between the farm value and the retail value includes value that was added by processing/packaging and transportation to locations near consumers. Compared to other states in the U.S., New Mexico has a relatively small number of food manufacturers, with 266 in the state in 2023, ranking 41st in the country in terms of establishments (Zachary, 2023). But food manufacturing is an important part of New Mexico’s overall manufacturing industry. In 2021, sales from food manufacturers were more than $4 billion ($4,052,749,000), representing just over one-quarter of the state’s more than $15 billion ($15,603,122,000) manufacturing sales (Census, 2021). Two-thirds (67.8%) of the state’s food manufacturing sales were associated with dairy products, e.g., cheese. For more information, contact Dr. Jay Lillywhite at lillywhi@nmsu.edu. |
 |
EXTENSION FAMILY & CONSUMER SCIENCES |
Strong NMSU Representation at the JCEP Extension Leadership Conference The Joint Council of Extension Professionals annual Extension Leadership Conference was held in Tampa, Florida on February 14-15, 2024. This year’s theme was Year Round Leadership. Karl Bradley, Leadership and Team Development Specialist for the Cooperative Extension Service was the keynote and capstone speaker discussing how to “follow out front” as a leader through being authentic, transparent, and humble in leadership. NMSU Extension had six agents attend, representing the various organizations that comprise JCEP membership, demonstrating the commitment to state and national leadership by New Mexican agents. Family and Consumer Sciences was represented by Rick Griffiths, currently the National Extension Association of Family and Consumer Sciences (NEAFCS) President, Dianne Christensen, the NEAFCS national Western Region Director, and Kellie Knight, the current NEAFCS New Mexico state affiliate president. Both Rick and Dianne served on the JCEP Planning Team. Dianne commented, “It was a pleasure to serve on a national conference planning team and connect with colleagues around the country and then come together and work for the common goal of executing an outstanding conference.” Christensen also presented a poster session on the EFCS Statewide Webinar Teams. Attending the JCEP ELC and PILD Conferences offers excellent opportunities to see the larger Extension perspective through the various member organizations and provides national networking and professional development. For more information, contact Dianne Christensen at diannec@nmsu.edu |
 |
|
|
INNOVATIVE MEDIA, RESEARCH & EXTENSION |
5.7 million uses of ACES IMRE multimedia products in 2023 The Department of Innovative Media, Research and Extension creates research-based educational products for New Mexico and with private and public partners around the U.S. and internationally. For more than 30 years, the team of artists, animators, researchers, instructional technology specialists, and programmers has been developing these multimedia tools for diverse audiences on a wide variety of topics. Their educational video games, web tools, videos, animations, and mobile apps reflect collaboration with subject matter experts at NMSU and elsewhere. (See http://innovativemedia.nmsu.edu for a sampling of products.) In 2023, users accessed these learning tools 5.7 million times, including 4.5 million plays of interactive modules and educational games, 812,031 views on YouTube, and 367,691 app downloads. Top-performing products include math games (mathsnacks.org), healthy eating and movement apps for early childhood (foodsandmoves.org), videos about hand washing (handwashing.nmsu.edu), and the Science of Agriculture collection (scienceofagriculture.org), which includes soil analysis, irrigation technology, nitrogen in feed and fertilizer, food science, and more. The team is proud to note continued strong usage of the web tool Selected Plants of Navajo Rangelands (navajorange.nmsu.edu), which was accessed 21,474 times in 2023 from around the US. The tool provides a searchable plant database with plant names given in spoken and written Navajo as well as in English. It was developed in collaboration with Gerald Moore, former Coordinating Extension Agent of Navajo Tri-State Federally Recognized Tribal Extension Program (now retired). |
 |
PLANT & ENVIRONMENTAL SCIENCES |
2024 Pedometrics Conference The Pedometrics 2024 conference welcomed 74 in-person and 20 remote participants from 22 countries to the campus of New Mexico State University from Feb 5–9th, 2024 to discuss recent advances and progress on long-standing challenges in the field of Pedometrics. Pedometrics is a commission of the International Union of Soil Sciences (IUSS) Division 1 “Soil in Space and Time”, which convenes soil and environmental scientists who apply the use of statistical and mathematical tools to analyze and interpret soil data. Conference attendees consisted of a wide range of individuals from experienced Pedometricians involved in the field for decades to 24 graduate students beginning their own research. The conference was structured around the “Ten challenges for the future of Pedometrics” (Wadoux et al, 2021; Table 1). Three four-hour intensive training workshops were held the day before the meeting that covered “Containers for reproducible Digital Soil Mapping at different scales”, “Assessment of spatial patterns of soil properties predictions”, and “Deep learning for soil spectroscopy”. A significant benefit of international conference participation is to networking with colleagues and potential collaborators. This was facilitated through two half day field trips and four social events. The first field trip highlighted soils developing in modern floodplain alluvium, ancestral Rio Grande alluvium, and piedmont slope alluvium derived from Organ Mountain Rhyolite. The second field trip demonstrated piedmont slope alluvium derived from Organ Mountain Monzonite followed by a field trip to White Sands National Park, where participants discussed the influence of ground water chemistry on dune formation and soil formation, as well as participated in sand sledding. Additionally, participants enjoyed a welcoming social, were taught American-style football and played a friendly game of both football and soccer, participated in an early morning run near the Organ Mountains, and enjoyed a museum tour and dancing during the conference dinner held at the New Mexico Farm and Ranch Heritage Museum. Overall, participants enjoyed presentations on cutting-edge Pedometrics research, in-depth topical discussion, arid-land soils, and extensive collaborative opportunities among peers. For more information, contact Dr. Colby Brungard at cbrung@nmsu.edu or click on the following link: Pedometrics experts worldwide convene in Las Cruces to tackle future challenges in soil science | ISRIC |
 |
IUSS-Pedometrics meeting field tour at White Sands National Park, February 8, 2024 |
SCHOOL OF HOTEL, RESTAURANT & TOURISM MANAGEMENT |
General Manager Appointed For Home2 Suites By Hilton Alamogordo White Sands Total Management Systems, Inc. (TMS) announced Kathryn Voelz as General Manager for Home2 Suites by Hilton Alamogordo White Sands. A proud New Mexico State University’s HRTM alumni, she brings a wealth of industry knowledge and proven track record of success to her new role. She will oversee day-to-day hotel operations while maximizing efforts on enhancing operational efficiency, hotel sales, marketing & revenue, increasing guest satisfaction, and employee development within the hotel. Kathryn’s journey with the hospitality industry began as an intern at Courtyard by Marriott Las Cruces at NMSU, where she quickly demonstrated her dedication and passion for the field. Over the years, she has steadily ascended through various roles, showcasing her exceptional skills and commitment to excellence. Her diverse experience includes front desk operations, sales coordination, and assistant general management. Kathryn is the first candidate in the Total Management Systems / NMSU HRTM Manager in Training Program to be promoted to General Manager of one of TMS Properties. General Manager Appointed for Home2 Suites by Hilton Alamogordo White Sands - Total Management Systems, Inc. (tmsnm.com) |
|
|
Annual Career Fair with the School of Hotel, Restaurant and Tourism Management and the College of ACES We are celebrating another successful year of our Annual Career Fair hosted by the HRTM program that took place on February 22nd at the Las Cruces Convention Center. This year we had the pleasure of welcoming 27 companies to introduce to our students, with over a third of the professionals in attendance being alumni. The significance of seeing these proud Aggies who have used their education to achieve career success in the hospitality industry and are now returning to hire current students and upcoming graduates and foster their development is truly the greatest marker of success we could have hoped for. Our partnerships include other disciplines within the College of ACES as well as industry supporters throughout New Mexico, El Paso, and on a national scale. Our pursuit to continue the mutually beneficial relationships between our industry partners and alumni to provide hands–on, practical experience as part of our students education is invaluable. We hope to continue to expand to benefit to the College of ACES and related areas such as the Business College, DACC and EPCC for years to come. To learn more about all the companies that attended, please visit our website at https://hrtm.nmsu.edu/employment/fair.html. |
 |
Click on the following link to give to the College of ACES. Give Now | New Mexico State University Foundation (nmsu.edu) You can also contact Planning Officer, Erika De La O. Medina at erikadlo@nmsu.edu for more information on how to give to the College of ACES. |
The College of Agricultural, Consumer, and Environmental Sciences (ACES) annual report provides an overview of accomplishments during 2022, including impacts, productivity and goals for each unit, area and program. These accomplishments reflect our work in teaching, research and extension. To view our College of ACES 2022 Annual Report click on the following link: Annual Reports | New Mexico State University - BE BOLD. Shape the Future. (nmsu.edu) |
 |
Meet Sunshine Tso, an agriculture major at NMSU. Sunshine said being away from her sacred land to attend college 400 miles away was one of the most difficult and loneliest things to deal with it, but because of the American Indian Programs, she felt like she was at home at NMSU. Sunshine decided to attend NMSU because of her passion for agriculture that runs through her ancestral history. She explains that as Navajos, they live off the land, respect agriculture, what grows and what lives, and would like to incorporate that into more of their traditional teaching. As a youth, Sunshine had mentors and teachers who influenced her greatly in agriculture, and she would like to be that person for other Native youths. To view her video jouney click on the following link: NMSU Journeys: Sunshine Tso - NMSU Journeys (wistia.com) |
COLLEGE OF ACES MAGAZINE – FALL 2023 ISSUE |
|
|
The College of Agriculture, Consumer and Environmental Sciences is an engine for economic and community development in New Mexico, improving the lives of New Mexicans through academic, research, and Extension programs. |
|
|
| |